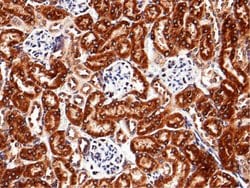
Invitrogen RAP Recombinant Rabbit Monoclonal Antibody (009) 100 &mu;L;

Learn More
Invitrogen™ RAP Recombinant Rabbit Monoclonal Antibody (009)


Description
This product is preservative free. It is recommended to add sodium azide to avoid contamination (final concentration 0.05%-0.1%). Recombinant rabbit monoclonal antibodies are produced using in vitro expression systems. The expression systems are developed by cloning in the specific antibody DNA sequences from immunoreactive rabbits. Then, individual clones are screened to select the best candidates for production. The advantages of using recombinant rabbit monoclonal antibodies include: better specificity and sensitivity, lot-to-lot consistency, animal origin-free formulations, and broader immunoreactivity to diverse targets due to larger rabbit immune repertoire. This antibody has specificity for Mouse LRPAP1.

Specifications
Specifications
| Antigen | RAP |
| Applications | ELISA, Immunohistochemistry (Paraffin), Immunoprecipitation, Western Blot, Immunocytochemistry |
| Classification | Recombinant Monoclonal |
| Clone | 009 |
| Concentration | 5 mg/mL |
| Conjugate | Unconjugated |
| Formulation | PBS with no preservative |
| Gene | Lrpap1 |
| Gene Accession No. | P55302 |
| Gene Alias | 39 kDa receptor-associated protein; A2MRAP; A2RAP; AA617339; AI790446; Alpha-2-macroglobulin receptor-associated protein; Alpha-2-macroglobulin receptor-associated protein precursor (Alpha-2-MRAP) (Low density lipoprotein receptor-related protein-associated protein 1) (RAP) (Heparin binding protein-44) (HBP-44); alpha-2-MRAP; AU042172; C77774; gp330-binding 45 kDa protein; HBP44; HBP-44; heparin-binding protein 44; LDL receptor related protein associated protein 1; low density lipoprotein receptor related protein, associated protein 1; low density lipoprotein receptor-related protein associated protein 1; low density lipoprotein receptor-related protein-associated protein 1; low density lipoprotein-related protein-associated protein 1 (alpha-2-macroglobulin receptor-associated protein 1); Lrpap1; MRAP; MYP23; RAP |
| Show More |
By clicking Submit, you acknowledge that you may be contacted by Fisher Scientific in regards to the feedback you have provided in this form. We will not share your information for any other purposes. All contact information provided shall also be maintained in accordance with our Privacy Policy.